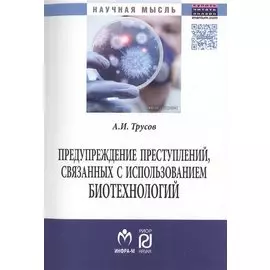
Предупреждение преступлений, связанных с использованием биотехнологий. Монография

-
 Инфра-М2227 ₽1759 ₽-21%
Инфра-М2227 ₽1759 ₽-21%Теоретические основы социологии права | В монографии рассматриваются важнейшие проблемы теории социологии права. К их числу относятся сущность социологического подхода к праву, его значение для различ...
-
 Инфра-М1638 ₽
Инфра-М1638 ₽Субъекты современного международного права. Монография | От субъектов международного права, являющихся носителями прав и обязанностей и, следовательно, определяющих направление развития современного м...
-
 Инфра-М1500 ₽1110 ₽-26%
Инфра-М1500 ₽1110 ₽-26%Антология Российской естественно-правовой мысли. Том 3. Монография | В третьем томе предлагаемой антологии содержится оценка философско-правовых взглядов, а также представлены полностью или в виде фра...
-
 Инфра-М1481 ₽
Инфра-М1481 ₽Институт административной ответственности несовершеннолетних в России. Монография | В монографии рассмотрены особенности института административной ответственности несовершеннолетних в Российской Феде...
-
 Инфра-М2983 ₽
Инфра-М2983 ₽Основы патентоведения. Учебное пособие | В учебном пособии изложены основы изобретательства, патентоведения, рационализации, правовой охраны и методы защиты объектов интеллектуальной и промышленной со...
-
 Инфра-М2532 ₽2000 ₽-21%
Инфра-М2532 ₽2000 ₽-21%Правовое регулирование стратегического планирования в сфере государственных финансов | В монографии проведено теоретическое исследование правового регулирования государственного финансового планирован...
-
 Инфра-М1662 ₽1247 ₽-24%
Инфра-М1662 ₽1247 ₽-24%Правовые основы организации взаимного страхования в России. Проблемы теории и практики | В монографии рассматриваются правовая сущность взаимного страхования, история его возникновения и развития от А...
-
 Инфра-М1587 ₽
Инфра-М1587 ₽Будущее права. Наследие академика В.С. Степина и юридическая наука | Предлагаемая вниманию читателя книга — дань памяти и уважения академику Российской академии наук Вячеславу Семёновичу Стёпину — выд...
-
![Гражданский процесс. Лекции]() Инфра-м421 ₽
Инфра-м421 ₽Гражданский процесс. Лекции | Книга представляет собой курс лекций по общей части гражданского процессуального права России. Лекционный материал изложен кратко, доступно и снабжен примерами. Он максим...
-
![Административное право и административная ответственность. Курс лекций]() Инфра-М2929 ₽
Инфра-М2929 ₽Административное право и административная ответственность. Курс лекций | Курс лекций соответствует программам административного права для студентов, обучающихся по направлению подготовки бакалавров «Ю...
-
![Зарождение и развитие международного частного права (XII-XX века)]() Инфра-М1441 ₽
Инфра-М1441 ₽Зарождение и развитие международного частного права (XII-XX века) | В монографии рассматриваются вопросы зарождения, становления и развития международного частного права (МЧП) как науки и самостоятель...
-
![Уголовное право и "цифровая преступность". Проблемы и решения. Монография]() Инфра-М1719 ₽
Инфра-М1719 ₽Уголовное право и "цифровая преступность". Проблемы и решения. Монография | Монография посвящена комплексу теоретико-прикладных проблем приспосабливания отечественного механизма уголовно-правовой охра...
-
![Теория государства и права. Учебник]() Инфра-М1999 ₽
Инфра-М1999 ₽Теория государства и права. Учебник | В настоящем учебнике дисциплина «Теория государства и права» изложена в соответствии с федеральным государственным образовательным стандартом высшего профессионал...
-
![Жилищное право Российской Федерации. Учебное пособие. Второе издание]() Инфра-М1379 ₽
Инфра-М1379 ₽Жилищное право Российской Федерации. Учебное пособие. Второе издание | В пособии на основе современного жилищного законодательства раскрываются основные понятия и институты жилищного права Российской ...
-
![Прокурорский надзор в Российской Федерации (в схемах). Учебное пособие]() Инфра-М1111 ₽
Инфра-М1111 ₽Прокурорский надзор в Российской Федерации (в схемах). Учебное пособие | Учебное пособие посвящено основным вопросам, изучаемым в рамках дисциплины «Прокурорский надзор в Российской Федерации», состав...
-
![Правоохранительные и судебные органы: учебное пособие]() Инфра-М2241 ₽
Инфра-М2241 ₽Правоохранительные и судебные органы: учебное пособие | Учебное пособие подготовлено на основе обновленного российского законодательства, имеющего значение для организации и функционирования правоохра...
-
![Юридические лица в Российском гражданском праве. В 3-х томах. Том 2. Виды юридических лиц в Российском законодательстве. Монография]() Инфра-М2735 ₽
Инфра-М2735 ₽Юридические лица в Российском гражданском праве. В 3-х томах. Том 2. Виды юридических лиц в Российском законодательстве. Монография | Второй том монографии «Юридические лица в российском гражданском п...
-
![Допустимые пределы ограничения авторских прав в контексте отечественного, зарубежного и международного права: Монография]() Инфра-М1662 ₽
Инфра-М1662 ₽Допустимые пределы ограничения авторских прав в контексте отечественного, зарубежного и международного права: Монография | Монография посвящена исследованию проблемы определения допустимых пределов ог...
-
![Оперативно-розыскная информация. Монография]() Инфра-М3456 ₽
Инфра-М3456 ₽Оперативно-розыскная информация. Монография | Впервые в открытой печати представлены уникальные результаты научных исследований в сфере информационного обеспечения оперативно-розыскной деятельности ор...
-
![Административное право. Учебник]() Инфра-М2772 ₽
Инфра-М2772 ₽Административное право. Учебник | В учебнике рассматриваются: предмет и метод административного права; административно-правовые нормы и отношения; соотношение государственного управления и исполнитель...
-
![Кредитный анализ в коммерческом банке. Учебное пособие]() Инфра-М1700 ₽1275 ₽-25%
Инфра-М1700 ₽1275 ₽-25%Кредитный анализ в коммерческом банке. Учебное пособие | В учебном пособии рассмотрены основные вопросы, связанные с организацией процесса кредитного анализа в коммерческом банке, показана роль кредит...
-
![Актуальные проблемы гражданского права. Учебное пособие]() Инфра-М1662 ₽
Инфра-М1662 ₽Актуальные проблемы гражданского права. Учебное пособие | Учебное пособие содержит проблемные вопросы курса гражданского права. Особое внимание уделено вещному и обязательственному праву, а также отве...
-
![Актуальные проблемы налогового права. Учебник]() Инфра-М3126 ₽
Инфра-М3126 ₽Актуальные проблемы налогового права. Учебник | Ценность книги определяется не только глубиной теоретического исследования, но и практической значимостью для юриста, имеющего дело с применением налого...
-
![Конституционно-правовое обеспечение национальной безопасности Российской Федерации]() Инфра-М3289 ₽
Инфра-М3289 ₽Конституционно-правовое обеспечение национальной безопасности Российской Федерации | Учебник посвящен конституционно-правовой основе (понятию, историческим особенностям становления и развития конститу...
-
![Гражданское право: учебник: в 2-х томах. Том 1]() Инфра-М3705 ₽
Инфра-М3705 ₽Гражданское право: учебник: в 2-х томах. Том 1 | В первом томе учебника, подготовленного в соответствии с учебной программой по дисциплине "Гражданское право" для образовательных организаций высшего о...
-
![Правовой механизм реализации амнистии в Российской Федерации и социальные последствия ее применения: монография]() Инфра-М1855 ₽
Инфра-М1855 ₽Правовой механизм реализации амнистии в Российской Федерации и социальные последствия ее применения: монография | Монография посвящена правовому механизму реализации и социальным последствиям применен...
-
![Правовые основы государственной власти в Испании]() Инфра-М731 ₽
Инфра-М731 ₽Правовые основы государственной власти в Испании | Монография посвящена вопросам регулирования управленческого процесса в Испании, системы и структуры органов публичной администрации, обжалования дейс...
-
![Основания наследования в гражданском праве Российской Федерации]() Инфра-М833 ₽
Инфра-М833 ₽Основания наследования в гражданском праве Российской Федерации | Монография посвящена системному изучению оснований наследования по законодательству Российской Федерации. .В монографии выработаны тео...
-
![Европейское право. Учебное пособие]() Инфра-М1631 ₽
Инфра-М1631 ₽Европейское право. Учебное пособие | В учебном пособии для подготовки бакалавров экономики и юриспруденции рассматривается процесс правового регулирования общественных отношений в Европейском союзе, в...
-
![Апелляция, кассация, надзор по гражданским делам. Учебное пособие]() Инфра-М3049 ₽
Инфра-М3049 ₽Апелляция, кассация, надзор по гражданским делам. Учебное пособие | В учебном пособии излагаются и анализируются теоретические положения о проверке и пересмотре судебных актов в гражданском судопроизв...
-
![Территории с особым статусом в составе федеративных государств. Конституционно-правовое исследование]() Инфра-М1642 ₽1232 ₽-24%
Инфра-М1642 ₽1232 ₽-24%Территории с особым статусом в составе федеративных государств. Конституционно-правовое исследование | В монографии комплексно рассмотрены конституционно-правовые статусы территорий с особым статусом ...
-
![Международно-правовые основы сотрудничества государств по противодействию незаконному обороту медицинской продукции. Монография]() Инфра-М1481 ₽
Инфра-М1481 ₽Международно-правовые основы сотрудничества государств по противодействию незаконному обороту медицинской продукции. Монография | Монография посвящена исследованию международных основ сотрудничества г...
-
![Виндикационное правоотношение: Монография]() Инфра-М957 ₽679 ₽-29%
Инфра-М957 ₽679 ₽-29%Виндикационное правоотношение: Монография | Монография посвящена исследованию виндикационного правоотношения — правоотношения, возникающего в случае утраты обладателем вещного права владения своим иму...
-
![История государства и права зарубежных стран. Учебник]() Инфра-М4176 ₽
Инфра-М4176 ₽История государства и права зарубежных стран. Учебник | Учебник подготовлен в соответствии с Государственным образовательным стандартом по высшему образованию и учебной программой по дисциплине «Истор...
-
![Судейский корпус России: совершенствование механизма формирования]() Инфра-М2669 ₽2086 ₽-21%
Инфра-М2669 ₽2086 ₽-21%Судейский корпус России: совершенствование механизма формирования | В монографии рассматриваются проблемы организационно-правового механизма отбора кандидатов на должности судей и наделения их судейск...
-
![Деструктивное воздействие на несовершеннолетних: теория и практика противодействия: монография]() Инфра-М1642 ₽1228 ₽-25%
Инфра-М1642 ₽1228 ₽-25%Деструктивное воздействие на несовершеннолетних: теория и практика противодействия: монография | В монографии с учетом научно-правового анализа, опыта практической и общественной деятельности проведен...
-
![Исполнительное производство. Учебник]() Инфра-М1481 ₽
Инфра-М1481 ₽Исполнительное производство. Учебник | В учебнике рассматриваются весь процесс принудительного исполнения судебных актов судебными приставами-исполнителями, такие важнейшие институты исполнительного п...
-
![Политика, основанная на знаниях, в контексте роста международного авторитета России (статьи, лекции, выступления и экспертные оценки политических решений)]() Инфра-М1354 ₽
Инфра-М1354 ₽Политика, основанная на знаниях, в контексте роста международного авторитета России (статьи, лекции, выступления и экспертные оценки политических решений) | В книге в рамках развития системы открытого...
-
![Дефекты правового регулирования охраны окружающей среды Монография]() Инфра-М1520 ₽
Инфра-М1520 ₽Дефекты правового регулирования охраны окружающей среды Монография | В монографии исследуются дефекты в экологическом праве, в частности несовершенства эколого-правовых идей, норм и нормативных правов...
-
![Проблемы обеспечения и защиты публичных интересов. Сборник научных статей]() Инфра-М731 ₽
Инфра-М731 ₽Проблемы обеспечения и защиты публичных интересов. Сборник научных статей | В сборнике представлены научные статьи, посвященные актуальным вопросам обеспечения и зашиты публичных интересов в сфере про...
-
![Правовая патопсихология. Учебное пособие]() Инфра-М2744 ₽2168 ₽-20%
Инфра-М2744 ₽2168 ₽-20%Правовая патопсихология. Учебное пособие | Традиционно понимаемые рамки дисциплины "Судебная психиатрия" в образовательном и правовом поле стремительно расширяются. Юридически релевантными становятся ...
-
![Искусственный разум, правовая система и функции государства. Монография]() Инфра-М2347 ₽1854 ₽-21%
Инфра-М2347 ₽1854 ₽-21%Искусственный разум, правовая система и функции государства. Монография | В монографии рассматриваются методологические проблемы встраивания искусственного разума в правовую систему с учетом закономер...
-
![Learn SOLAS 74 & MARPOL 73/78 = Морские конвенции СОЛАС 74 и МАРПОЛ 73/78. Учебное пособие]() Инфра-М3308 ₽2613 ₽-21%
Инфра-М3308 ₽2613 ₽-21%Learn SOLAS 74 & MARPOL 73/78 = Морские конвенции СОЛАС 74 и МАРПОЛ 73/78. Учебное пособие | Учебное пособие содержит детально разработанный практикум, который помогает студентам изучить положения осн...
-
![Национальное и международно-правовое регулирование противодействия торговле людьми и рабству в их современных формах. Монография]() Инфра-М3262 ₽2577 ₽-20%
Инфра-М3262 ₽2577 ₽-20%Национальное и международно-правовое регулирование противодействия торговле людьми и рабству в их современных формах. Монография | Монография посвящена рассмотрению таких явлений в современном мире, к...
-
![Задачи уголовной политики. Преступление как социально-патологическое явление]() Инфра-М947 ₽
Инфра-М947 ₽Задачи уголовной политики. Преступление как социально-патологическое явление | В сборник работ выдающегося немецкого ученого Франца фон Листа (1851-1919), основателя Международного союза уголовного пр...
-
![Административное право. Практикум. Учебное пособие]() Инфра-М1599 ₽
Инфра-М1599 ₽Административное право. Практикум. Учебное пособие | Практикум по дисциплине «Административное право» по программам среднего профессионального образования охватывает 14 тем (Общую часть административн...
-
![Оценка стоимости прав требования: Учебное пособие]() Инфра-М2202 ₽1647 ₽-25%
Инфра-М2202 ₽1647 ₽-25%Оценка стоимости прав требования: Учебное пособие | В учебном пособии разграничены понятия, используемые при оценке, — право требования, обязательство (долг), дебиторская задолженность. Раскрыто, что ...
-
![Понятие и взаимодействие международной и национальных правовых систем. Монография]() Инфра-М1951 ₽
Инфра-М1951 ₽Понятие и взаимодействие международной и национальных правовых систем. Монография | В монографии рассматриваются вопросы развития концепции правовой системы в общей теории права и международно-правово...
-
![Защита социальных прав граждан. Теория и практика. Монография]() Инфра-М1971 ₽
Инфра-М1971 ₽Защита социальных прав граждан. Теория и практика. Монография | В монографии рассматривается институт защиты в проекции к социальным правам и свободам человека и гражданина. Автор исследует механизм з...
-
![Законы из-за границы: Политико-правовые аспекты классического евразийства]() Инфра-М2262 ₽1787 ₽-20%
Инфра-М2262 ₽1787 ₽-20%Законы из-за границы: Политико-правовые аспекты классического евразийства | Автор работы впервые на теоретическом уровне исследует правовые и политические взгляды классиков евразийства (Н. С. Трубецко...
-
![Административное право. Учебное пособие]() Инфра-М4001 ₽3161 ₽-20%
Инфра-М4001 ₽3161 ₽-20%Административное право. Учебное пособие | В учебном пособии освещается место исполнительной власти в системе государственной власти Российской Федерации; рассматриваются понятие, предмет и методы адми...
-
![Координация деятельности субъектов права в условиях кризиса: Монография]() Инфра-М2029 ₽
Инфра-М2029 ₽Координация деятельности субъектов права в условиях кризиса: Монография | Монография посвящена поиску путей повышения эффективности государственного управления в условиях кризисных ситуаций. Прослежен...
-
![Сравнительное правоведение в условиях интеграции государств. Материалы II Международного конгресса сравнительного правоведения (Москва, 3 декабря 2012 года)]() Инфра-М753 ₽
Инфра-М753 ₽Сравнительное правоведение в условиях интеграции государств. Материалы II Международного конгресса сравнительного правоведения (Москва, 3 декабря 2012 года) | 3 декабря 2012 г. в Институте законодател...
-
![Вещное право. Учебное пособие]() Инфра-М1613 ₽
Инфра-М1613 ₽Вещное право. Учебное пособие | Учебное пособие знакомит читателя с проблемами современного российского законодательного регулирования вещных прав в целом и каждого вещного права в частности, перспект...
-
![Актуальные проблемы современного наследственного законодательства Российской Федерации: Монография]() Инфра-М1132 ₽804 ₽-28%
Инфра-М1132 ₽804 ₽-28%Актуальные проблемы современного наследственного законодательства Российской Федерации: Монография | Монография посвящена анализу самых актуальных проблем современного наследственного права России. Ра...
-
![Правоведение. Учебник]() Инфра-М3012 ₽
Инфра-М3012 ₽Правоведение. Учебник | В учебнике в доступной форме рассматриваются основные понятия теории государства и права, основные положения Конституции РФ и структура высших органов государственной власти, п...
-
![Организация работы органов и учреждений социальной защиты населения. Учебник]() Инфра-М2883 ₽
Инфра-М2883 ₽Организация работы органов и учреждений социальной защиты населения. Учебник | В учебнике рассмотрены основные вопросы курса «Организация работы органов и учреждений социальной защиты населения в Росс...
-
![Право социального обеспечения Росийской Федерации: Учеб. пособие / (Высшее образование). Сидоров В. (Инфра-М)]() Инфра-м690 ₽
Инфра-м690 ₽Право социального обеспечения Росийской Федерации: Учеб. пособие / (Высшее образование). Сидоров В. (Инфра-М) | Настоящее учебное пособие соответствует государственному образовательному стандарту высш...
-
![Административно-деликтное право. Учебное пособие]() Инфра-М2448 ₽1934 ₽-20%
Инфра-М2448 ₽1934 ₽-20%Административно-деликтное право. Учебное пособие | В пособии в соответствии с учебным планом дисциплины "Административная ответственность" проанализированы основные положения законодательства об админ...
-
![Предупреждение преступлений, связанных с использованием биотехнологий. Монография]() Инфра-М1214 ₽
Инфра-М1214 ₽Предупреждение преступлений, связанных с использованием биотехнологий. Монография | Биотехнологическая революция предоставила широкие возможности гуманистического использования результатов открытий. О...
-
![История государства и права зарубежных стран в схемах. Учебное пособие]() Инфра-М1194 ₽
Инфра-М1194 ₽История государства и права зарубежных стран в схемах. Учебное пособие | Пособие представляет собой сжатое изложение учебной дисциплины «История государства и права зарубежных стран», которая в соотве...
-
![Правовое обеспечение социальной работы. Учебник]() Инфра-М2384 ₽
Инфра-М2384 ₽Правовое обеспечение социальной работы. Учебник | В учебнике рассматриваются понятие и система правового обеспечения социальной работы, анализируются законодательство РФ и отдельных субъектов Федераци...
-
![Актуальные проблемы предпринимательского права. Выпуск II]() Инфра-М2280 ₽1710 ₽-25%
Инфра-М2280 ₽1710 ₽-25%Актуальные проблемы предпринимательского права. Выпуск II | В сборник статей, посвященный актуальным проблемам предпринимательского права, вошли научные труды выпускников и аспирантов юридического фак...
-
![Международное морское право. Частное и публичное. Учебник]() Инфра-М3221 ₽2518 ₽-21%
Инфра-М3221 ₽2518 ₽-21%Международное морское право. Частное и публичное. Учебник | Для студентов, аспирантов, преподавателей юридических вузов и факультетов, юристов — специалистов в сфере международного и морского права, а...
Учебники по праву Инфра-м
В категории "учебники по праву инфра-м" найдено товаров: 594 | Страница 2
Цена: